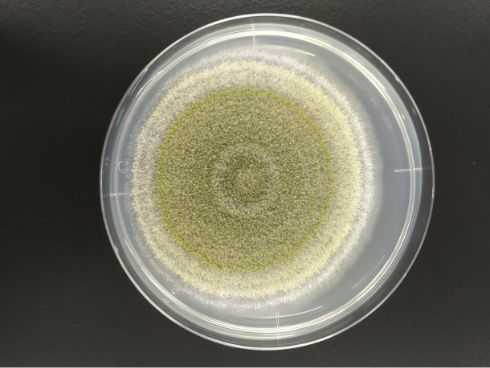

組織
食品科学研究所は、3つの研究部門(加工・利用ユニット、スポーツ・健康・機能ユニット、発酵・醸造ユニット)とリエゾンオフィスで構成され、プロジェクトに応じてアグリコース・ビジネスコース教員も交えて円滑に課題解決を遂行します。

ユニット研究領域
共通領域
- 未利用資源の探索と有効活用
- 品質・安全性評価技術の開発
- 環境負荷低減技術の開発
- SDGsに配慮した研究
加工・利用ユニット
- 食品加工技術の開発と改善
- 品質保持技術の開発
- 廃棄物の低減

素材・加工

安全・管理

製造・環境
スポーツ・健康・機能ユニット
- 食品素材の機能性探索
- 食品の栄養・おいしさ・機能性の評価
- 健康増進における食の役割解明

機能・評価

栄養・健康

成分・分析
発酵・醸造ユニット
- 地域微生物資源の探索と利活用
- 新規発酵食品と醸造微生物の開発
- 微生物による有用物質生産
微生物

発酵・醸造

酵素利用・分析